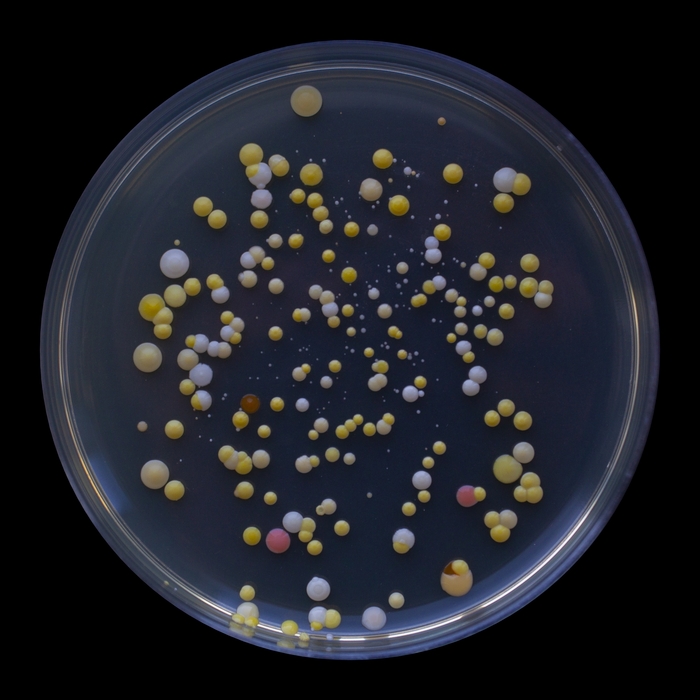
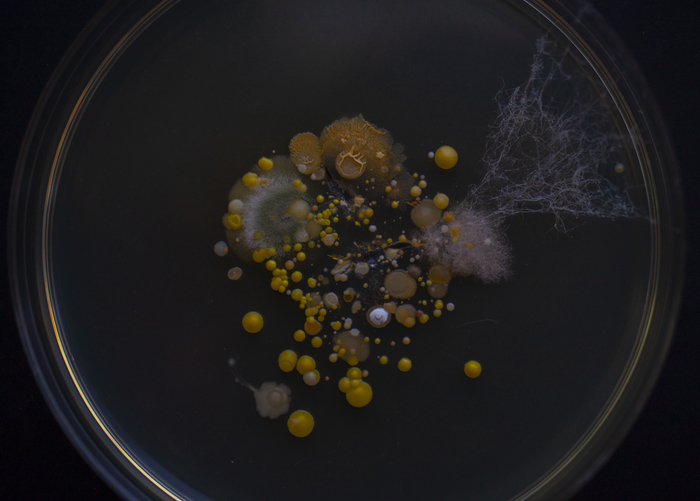
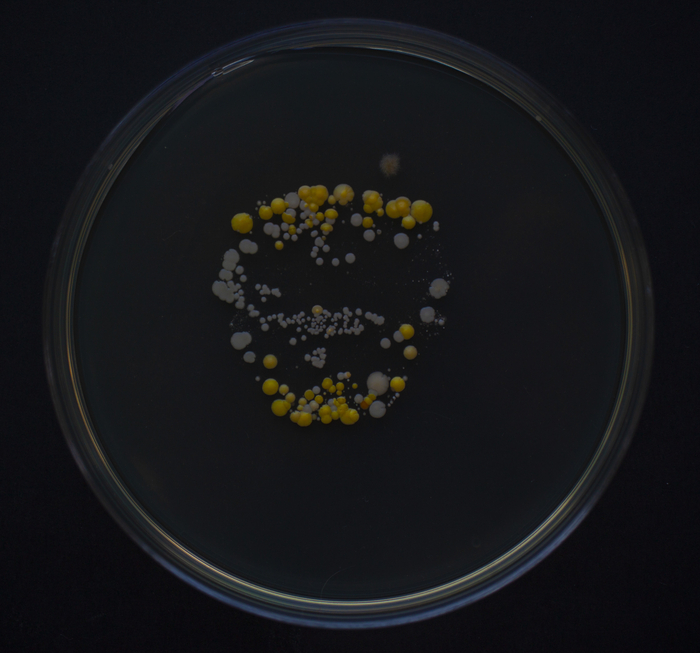

Красота плесени1
Всем привет:)
Меня зовут Александра и я микробиолог.
Расскажу небольшую историю.
Когда-то давно я, как и все люди, озадачилась вопросом «кем же все таки я стану, когда вырасту?». Очень любила биологию, так что было понятно, что жизнь нужно связать именно с ней. Но где же ее найти?
Я не хотела уходить в медицину, не хотела изучать что-то одно. А лечить… это же такая ответственность, что с людьми, что с животными. Тогда стало ясно, мне нужна именно биология, такая, которая изучает что-то.
Угадайте, куда меня занесло?) Я дипломированный почвовед))) Хочу сказать, что, да, я получила именно то, что искала. Но так уж вышло, что на факультете почвоведения был профиль сельскохозяйственной микробиологии.
Через пару лет мне надоели бактерии и я увлеклась микологией. Я проводила исследования связанные с защитой растений. Как это было увлекательно!
Постепенно, работа и хобби смешались. А еще я брала подработки, на одной из них мне посчастливилось познакомиться с очень интересным человеком, который еще и подарил мне способность «смотреть под другим углом».
Я устроилась в коммерческую организацию, которая занимается производством пестицидов и изучением объектов, с которыми мы боремся. Врага нужно знать в лицо:) А еще у нас есть фотоаппарат и макрообъектив.
Ребята, это просто чума, меня не остановить)
Я начала фоткать все что вижу, ведь всегда хочется разглядеть поближе.
А потом мне еще тот самый интересный человек одолжил свою зеркалку и помог выбрать макрообъектив) Мы находили в интернете профессиональные, невероятно красивые снимки грибов и он говорил «жду, когда ты начнёшь фоткать также».
Так вот, про плесень.
Она невероятна. Она бывает самых разных, невообразимых цветов, форм и ароматов, кстати тоже. Она может вылечить, может убить, может одурманить.
Плесень это грибы, просто микроскопические.
На моей работе есть отдел, который занимается фитоэкспертизой. Это когда мы берём любой объект и выделяем из него плесень, определяем и анализируем ее.
Тут-то мне и снесло башню.
На фото ниже мицелий Magnaporthe grisea, известного как возбудитель пирикуляриоза риса. Сломали язык?:) Ничего, привыкнете.
И он кажется таким простым, но на деле, этот гриб может уничтожать рис целыми плантациями. Он довольно легко распространяется и адаптируется под условия окружающей среды. Достаточно быстро вырабатывает устойчивость к фунгицидам (средства защиты растений от грибов) и когда нибудь, кроме профилактики, мало что сможет его сдержать.
Тут я вам покажу просто зернышко риса в плеснюхе, которая просто на нем находилась и проросла в благоприятных лабораторных условиях:
Красота, правда?:)
А вот всем известная зеленая плесень Penicillium, которая растет буквально везде: в чае, макаронах, забытых супах и компотах. В данном случае она поселилась на севке лука и начала убивать его самого и товарищей по сетке заодно.
Я могу рассказывать бесконечно долго, но, пожалуй, остановлюсь:)
Всем неплесневых продуктов:)